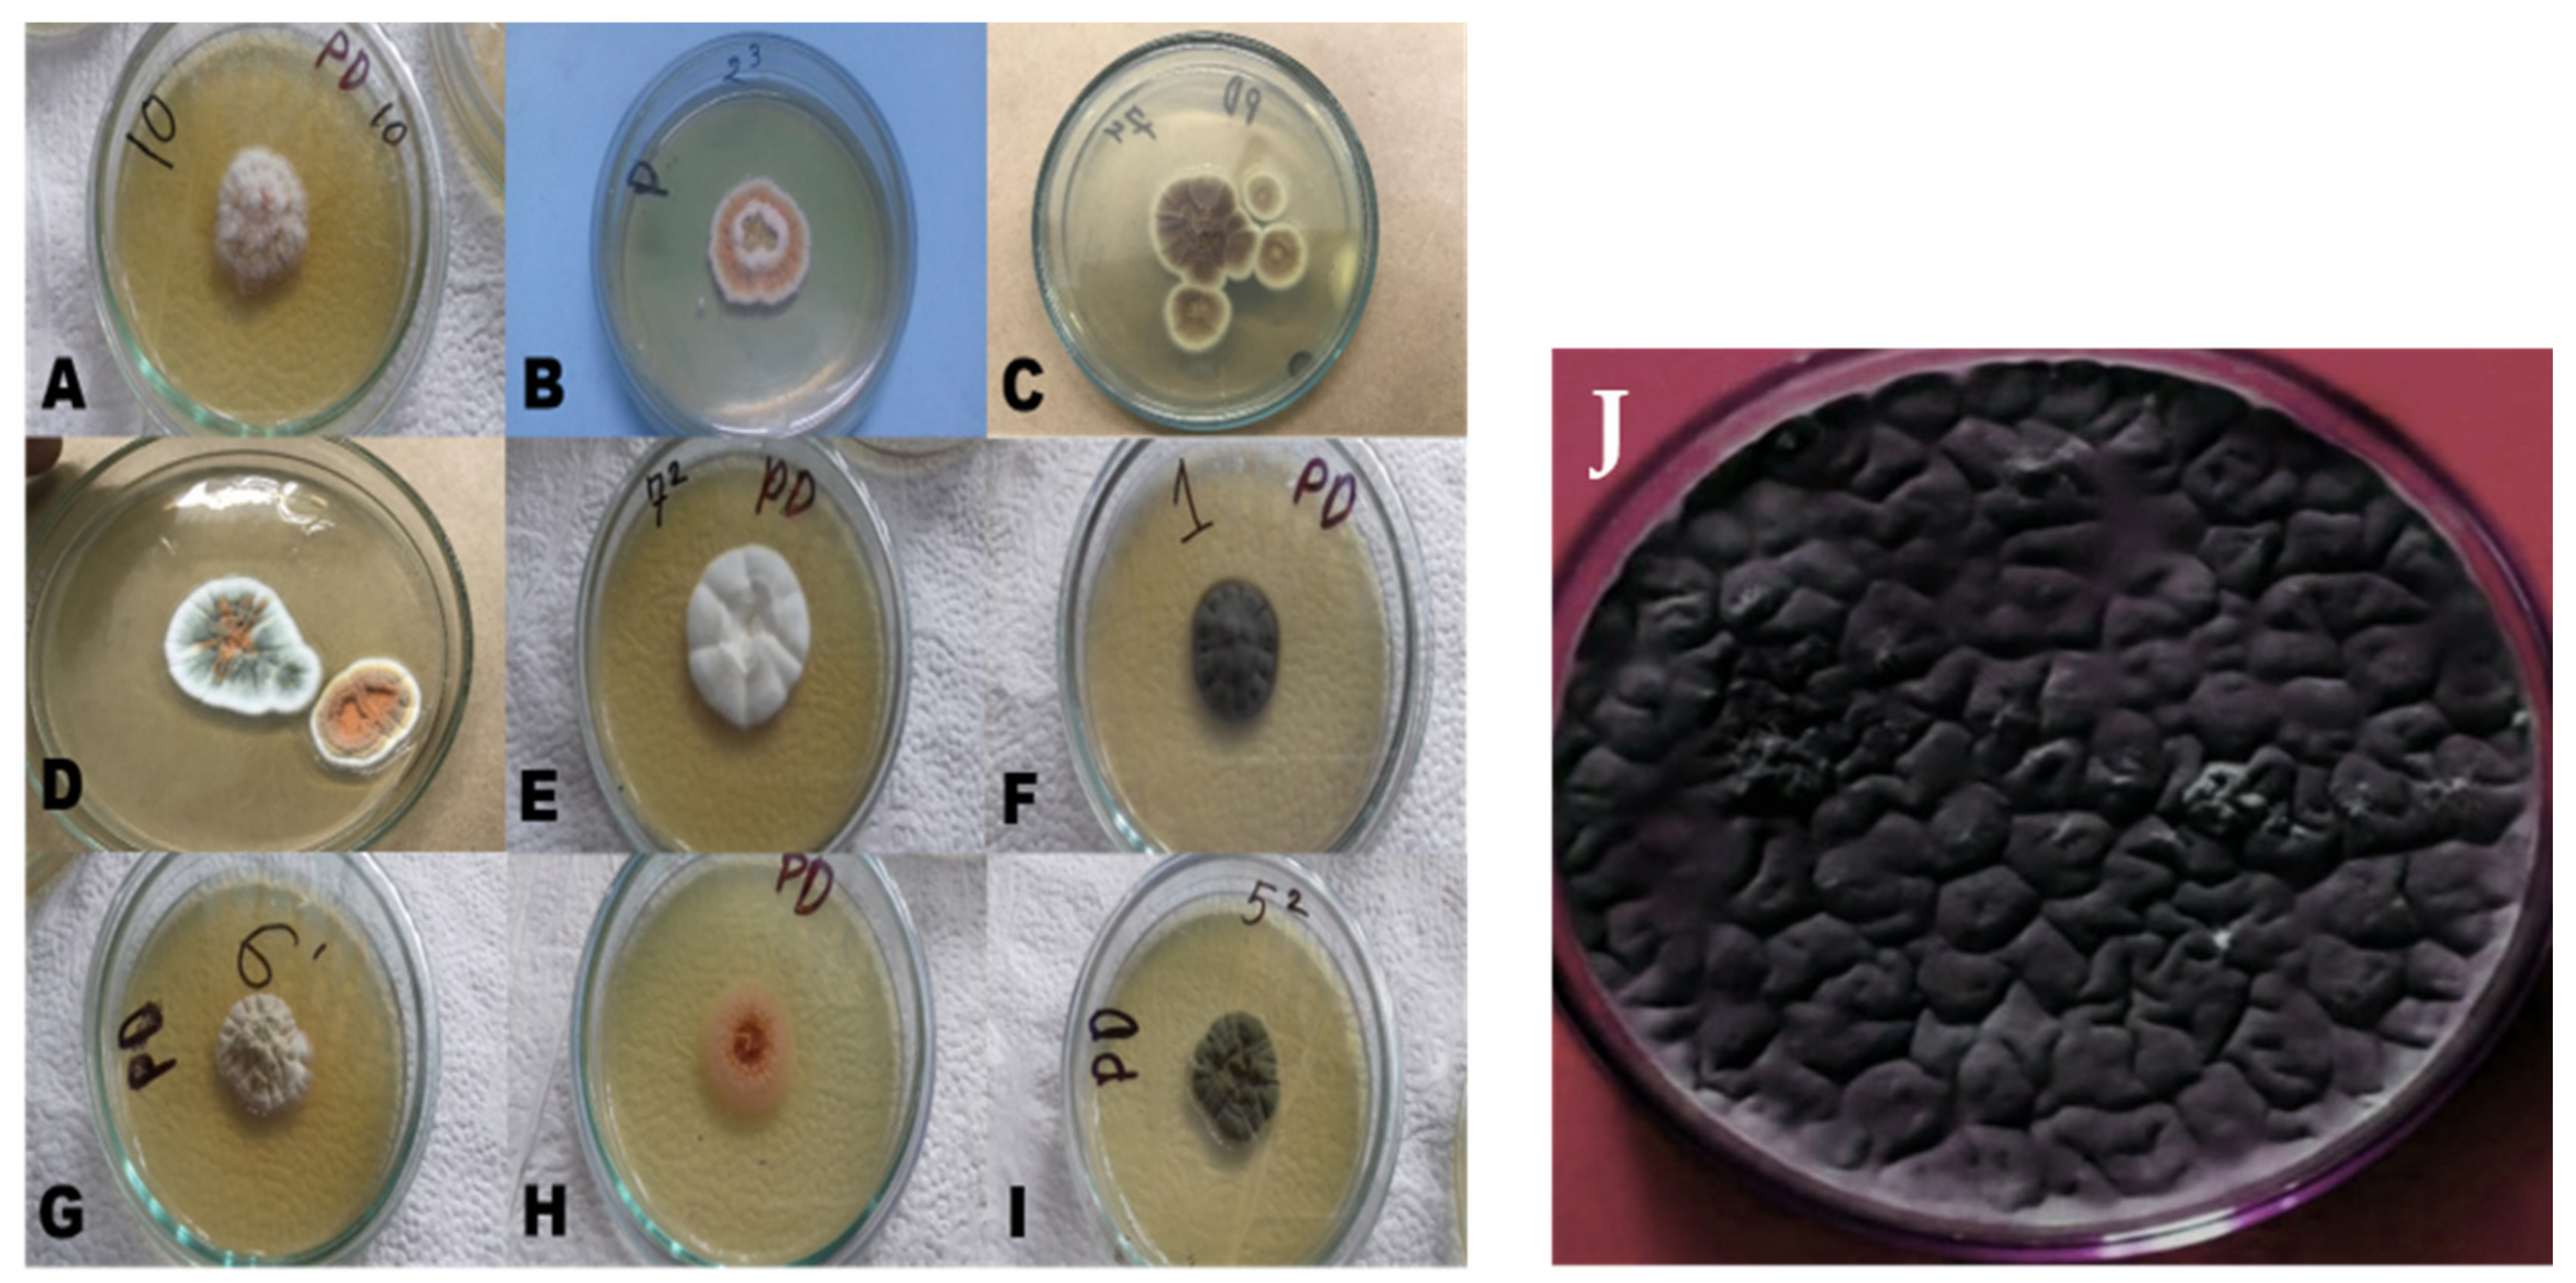

Isolation and Identification of Natural Colorant Producing Soil-Borne Aspergillus niger from Bangladesh and Extraction of the Pigment
Abstract
1. Introduction
2. Materials and Methods
2.1. Collection of Soil Samples and Site Selection
2.2. Isolation of Fungal Strains from Soil Samples
2.3. Identification of Aspergillus niger
2.4. Pigment Production and Extraction from Aspergillus niger
2.4.1. Primary Culture of Aspergillus niger
2.4.2. Submerged Fermentation of Aspergillus niger
2.4.3. Pigment Extract Produced by Aspergillus niger
2.5. Detection of Fungal Pigment by Spectroscopic Analysis
2.6. In Vivo Test for Toxic Analysis of the Produced Pigments
2.7. Supplementation of Fungal Colorants in Food Products
2.7.1. Cookies
2.7.2. Lemon Juice
2.8. Assessment of Supplemented Fungal Colorant on Food Product Quality
2.8.1. Quantitative Colorimetric Analysis
2.8.2. Sensory Evaluation
2.9. Statistical Analysis
3. Results
3.1. Results of Isolation and Identification of Aspergillus niger
3.1.1. Isolation of Fungal Strains and Cultural Characterization of Aspergillus niger
3.1.2. Identification of Aspergillus niger by Observing Microscopic Morphology
3.1.3. Identification of Aspergillus niger by Polymerase Chain Reaction
3.2. Results of Aspergillus niger Fermentation
3.3. Spectroscopic Analysis of Brown Pigment and Absorbance in Solution
3.4. Results of Toxic Analysis Test
3.5. Quantitative Colorimetric Analysis of Pigments in Food Products
3.6. Sensory Evaluation of Fungal Pigment-Supplemented Food Products
4. Discussion
5. Conclusions
Author Contributions
Funding
Institutional Review Board Statement
Informed Consent Statement
Data Availability Statement
Conflicts of Interest
References
- Barrows, J.N.; Lipman, A.L.; Baily, C.J. Color Additives: FDA Regulatory Process and Historical Perspectives. Available online: https://www.food-safety.com/articles/4207-color-additives-fdas-regulatory-process-and-historical-perspectives (accessed on 1 May 2021).
- Downham, A.; Collins, P. Coloring our foods in the last and next millennium. Int. J. Food Sci. Technol. 2000, 35, 5–22. [Google Scholar] [CrossRef]
- Ramesh, C.; Vinithkumar, N.V.; Kirubagaran, R.; Venil, C.K.; Dufossé, L. Multifaceted applications of microbial pigments: Current knowledge, challenges and future directions for public health implications. Microorganisms 2019, 7, 186. [Google Scholar] [CrossRef]
- Venil, C.K.; Velmurugan, P.; Dufossé, L.; Devi, P.R.; Ravi, A.V. Fungal Pigments: Potential coloring compounds for wide ranging applications in textile dyeing. J. Fungi 2020, 6, 68. [Google Scholar] [CrossRef]
- Shatila, F.; Yusef, H.; Holail, H. Pigment production by Exiguobacterium aurantiacum FH, a novel Lebanese strain. Int. J. Curr. Microbiol. App. Sci. 2013, 2, 176–191. [Google Scholar]
- Kulkarni, P.; Gupta, N. Screening and evaluation of soil fungal isolates for xylanase production. Recent Res. Sci. Technol. 2013, 5, 33–36. [Google Scholar]
- Akilandeswari, P.; Pradeep, B.V. Exploration of industrially important pigments from soil fungi. Appl. Microbiol. Biotechnol. 2016, 100, 1631–1643. [Google Scholar] [CrossRef] [PubMed]
- Muniz, C.C.; Zelaya, T.E.C.; Esquivel, G.R.; Fernandez, F.J. Penicillin and cephalosporin production: A historical perspective. J. Microbiol. 2007, 49, 88–98. [Google Scholar]
- Sharmila, K.; Thillaimaharani, K.A.; Logesh, A.R.; Sathishkumar, A.; Kalaiselvam, M. Production of cyclosporin-A by saprophytic filamentous fungus Fusarium oxysporum. Int. J. Pharm. Sci. 2012, 4, 149–153. [Google Scholar]
- Singh, S.K.; Pandey, A. Emerging approaches in fermentative production of statins. Appl. Biochem. Biotechnol. 2013, 171, 927–938. [Google Scholar] [CrossRef] [PubMed]
- Asnaashari, M.; Ghanbary, M.A.T.; Tazick, Z. Optimization of penicillin G production by Penicillium chrysogenum. Ann. Biol. Res. 2012, 3, 5434–5440. [Google Scholar]
- Endo, A.; Kuroda, M.; Tsujita, Y. ML-236A, ML- 236B, ML-236C, new inhibitors of cholestrogenisis produced by Penicillium citrinium. J. Antibiot. 1997, 29, 1346–1348. [Google Scholar] [CrossRef]
- Dhale, M.A.; Divakar, S.; UmeshKumar, S.; Vijayalakshmi, G. Characterization of dehydromonacolin-MV2 from Monascus purpureus mutant. J. Appl. Microbiol. 2007, 103, 2168–2173. [Google Scholar] [CrossRef]
- Cho, Y.J.; Park, J.P.; Hwang, H.J.; Kim, S.W.; Choi, J.W.; Yun, J.W. Production of red pigment by submerged culture of Paecilomyces sinclairii. Lett. Appl. Microbiol. 2002, 35, 195–202. [Google Scholar] [CrossRef]
- Saeed, K.; Zafar, I.; Ghosia, L.; Bacha, N.; Khan, A.A.; Saeed, M.; Ali, M. Phytotoxic and herbicidal activities of Aspergillus and Penicillium species isolated from rhizosphere and soil. Pakistan J. Weed Sci. Res. 2014, 20, 293–303. [Google Scholar]
- Rai, H.; Battacharyya, M.S.; Singh, J.; Bansal, T.K.; Vats, P.; Banerjee, U.C. Removal of dyes from the effluent of textile and dyestuff manufacturing industry– A review of emerging techniques with reference to biological treatment. Crit. Rev. Environ. Sci. Technol. 2005, 35, 219–238. [Google Scholar] [CrossRef]
- Dufosse, L.; Fouillaud, M.; Caro, Y.; Mapari, S.A.S.; Sutthiwong, N. Filamentous fungi are large-scale producers of pigments and colorants for the food industry. Curr. Opin. Biotechnol. 2014, 26, 56–61. [Google Scholar] [CrossRef]
- Duffose, L. Pigments, Microbial. Encycl. Microbiol. 2009, 4, 457–471. [Google Scholar]
- Kalra, R.; Conlan, X.A.; Goel, M. Fungi as a potential source of pigments: Harnessing filamentous fungi. Front. Chem. 2020, 8, 369. [Google Scholar] [CrossRef]
- Mia, M.Y.; Hossain, M.U.; Farzana, S. Prospects and Constraints of Madhupur National Park Management. J. Environ. Sci. Nat. Resour. 2012, 5, 151–158. [Google Scholar] [CrossRef]
- Gain, P. The Last forests of Bangladesh, 2nd ed.; Society for Environment and Human Development (SHED): Dhaka, Bangladesh, 2002; pp. 1–224. [Google Scholar]
- Hoque, A.E.; Islam, A.K.M.N.; Huq, S.M.I. Seasonal variation of edaphic features of Madhupur Sal forest, Bangladesh. Ecoprint 2008, 15, 7–14. [Google Scholar] [CrossRef][Green Version]
- Fakruddin, M.; Chowdhury, A.; Hossain, M.N.; Ahmed, M.M. Characterization of aflatoxin producing Aspergillus flavus from food and feed samples. SpringerPlus 2013, 4, 159. [Google Scholar] [CrossRef]
- Sugita, C.; Makimura, K.; Uchida, K.; Yamaguchi, H.; Nagai, A. PCR identification system for the genus Aspergillus and three major pathogenic species: A. fumigatus, A. flavus and Aspergillus niger. Med. Mycol 2004, 42, 433–437. [Google Scholar] [CrossRef] [PubMed]
- Poorniammal, R.; Gunasekaran, S.; Sakthi, A.R. Production and application of natural food colorant from Thermomyces spp. Asian J. Dairy Food Res. 2015, 34, 130–135. [Google Scholar] [CrossRef]
- Jha, J.; Meenu, K.; Sinha, P. Microbial pigment as an alternative to synthetic dye. J. Young Sci. IRIS 2017, 7, 52–60. [Google Scholar]
- Hinch, E.M.; Robinson, S.C. Mechanical Color Reading of Wood-Staining Fungal Pigment Textile Dyes: An Alternative Method Determining Colorfastness. Coatings 2006, 6, 25. [Google Scholar] [CrossRef]
- Velmurugan, P.; Kamala, K.S.; Balachandar, V.; Lakshmanaperumalsamy, P.; Chae, J.C.; Oh, B.T. Natural pigment extraction from five filamentous fungi for industrial application and dyeing of leather. Carbohydr. Polym. 2010, 79, 262–268. [Google Scholar] [CrossRef]
- Goncalves, R.C.; Lisboa, H.C.; Pombeiro-Sponchiado, S.R. Characterization of melanin pigment produced by Aspergillus nidulans. World J. Microbiol. Biotechnol. 2012, 28, 1467–1474. [Google Scholar] [CrossRef]
- Liu, Y.; Zheng, W.; Ibrahim, S.A.; Yang, H.; Huang, W. Chemical properties of vacuum-fried Pleurotuseryngii during storage and characterization of brown pigment. Int. J. Food Prop. 2017, 20, 2349–2358. [Google Scholar] [CrossRef]
- Ali, M.Y.; Hassan, A.M.; Mohamed, Z.A.; Ramadan, M.F. Effect of food colorants and additives on the hematological and histological characteristics of albino rats. Toxicol. Environ. Health Sci. 2019, 11, 155–167. [Google Scholar] [CrossRef]
- Elekima, I.; Nwachuku, O.E. Evaluation of Acute and Chronic Toxicity of Tartrazine (E102) on Steriod Reproductive Hormones of Albino Rats. Asian J. Res. Rep. Endocrin. 2019, 1, 1–5. Available online: https://journalajrre.com/index.php/AJRRE/article/view/30095 (accessed on 1 May 2021).
- Begum, S.; Das, P.C.; Karmoker, P. Processing of mixed fruit juice from mango, orange and pineapple. Fund. Appl. Agric. 2018, 3, 440–445. [Google Scholar] [CrossRef]
- Mapari, S.A.S.; Meyer, A.S.; Thrane, U. Colorimetric characterization for comparative analysis of fungal pigments and natural food colorants. J. Agric. Food Chem. 2006, 54, 7028–7035. [Google Scholar] [CrossRef]
- Lucky, A.R.; Al-Mamun, A.; Hosen, A.; Toma, M.A.; Mazumder, M.A.R. Nutritional and sensory quality assessment of plain cake enriched with beetroot powder. Food Res. 2020, 4, 2049–2053. [Google Scholar] [CrossRef]
- FAO. The Future of Food and Agriculture–Trends and Challenges; Annual Report; Food and Agriculture Organization: Rome, Italy, 2017. [Google Scholar]
- Dufosse, L. Microbial production of food grade pigments. J. Food Tech. Biol. 2006, 44, 313–321. [Google Scholar]
- Ravimannan, N.; Sevvel, P.; Saarutharshan, S. Study on fungi associated with spoilage of bread. Int. J. Adv. Res. Biol. Sci. 2016, 3, 165–167. Available online: http://s-o-i.org/1.15/ijarbs-2016-3-4-23 (accessed on 1 May 2021).
- Devi, A.A. Extraction of natural dyes from fungus—an alternative for textile dyeing. J. Nat. Sci. Res. 2014, 4, 1–6. [Google Scholar]
- Ray, A.C.; Eakin, R.E. Studies on the biosynthesis of Aspergillin by Aspergillus niger. Appl. Microbiol. 1975, 30, 909–915. [Google Scholar] [CrossRef] [PubMed]
- Ponraj, M.; Jamunarani, P.; Zambare, V. Isolation and Optimization of Culture Conditions for Decolorization of True Blue Using Dye Decolorizing Fungi. Asian J. Exp. Biol. Sci. 2011, 2, 270–277. [Google Scholar]
- Guyomarch, F.; Binet, A.; Dufosse, L. Production of carotenoids by Brevibacterium linens: Variation among strains, kinetic aspects and HPLC profiles. J. Ind. Microbiol. Biotechnol. 2000, 24, 64–70. [Google Scholar] [CrossRef]
- Atalla, M.M.; Elkhrisy, E.A.M.; Ase, M.A. Production of textile reddish brown dyes by fungi. Malays. J. Microbiol. 2011, 7, 33–40. [Google Scholar]
- Bechtold, T. Handbook of Natural Colorants; John Wiley & Sons: Chichester, UK, 2009; Chapter 10; pp. 151–182. [Google Scholar]
- Zalar, P.; de Hoog, G.S.; Schroers, H.J.; Crous, P.W.; Groenewald, J.Z.; Gunde-Cimerman, N. Phylogeny and ecology of the ubiquitous saprobe Cladosporium sphaerospermum, with descriptions of seven new species from hyper saline environments. Stud. Mycol. 2007, 58, 157–183. [Google Scholar] [CrossRef] [PubMed]
- Sutthiwong, N.; Caro, Y.; Milhau, C.; Valla, A.; Fouillaud, M.; Dufosse, L. Arthrobacter arilaitensis strains isolated from ripened cheeses: Characterization of their pigmentation using spectrocolorimetry. Food Res. Int. 2014, 65, 184–192. [Google Scholar] [CrossRef]

| Sensory Parameters | Sensory Scores | LSD at 5% | Standard Error of the Mean (S.Em±) | |||
|---|---|---|---|---|---|---|
| Cookies | Lemon Juice | |||||
| Control | with Colorant | Control | with Colorant | |||
| Color and appearance | 6.89 ± 0.21 | 8.54 ± 0.53 | 6.51 ± 0.71 | 8.22 ± 0.38 | 0.534 | 0.601 |
| Flavor | 8.23 ± 0.43 | 8.36 ± 0.38 | 8.20 ± 0.75 | 8.38 ± 0.50 | 0.621 | 0.689 |
| Texture | 8.47 ± 0.10 | 8.61 ± 0.36 | 7.50 ± 0.45 | 7.57 ± 0.43 | 0.378 | 0.554 |
| Taste | 8.07 ± 0.25 | 8.40 ± 0.53 | 7.99 ± 0.91 | 8.13 ± 0.53 | 0.450 | 0.475 |
| Overall acceptability | 7.92 ± 0.19 | 8.48 ± 0.35 | 7.55 ± 0.23 | 8.08 ± 0.30 | 0.499 | 0.583 |
Publisher’s Note: MDPI stays neutral with regard to jurisdictional claims in published maps and institutional affiliations. |
© 2021 by the authors. Licensee MDPI, Basel, Switzerland. This article is an open access article distributed under the terms and conditions of the Creative Commons Attribution (CC BY) license (https://creativecommons.org/licenses/by/4.0/).
Share and Cite
Toma, M.A.; Nazir, K.H.M.N.H.; Mahmud, M.M.; Mishra, P.; Ali, M.K.; Kabir, A.; Shahid, M.A.H.; Siddique, M.P.; Alim, M.A. Isolation and Identification of Natural Colorant Producing Soil-Borne Aspergillus niger from Bangladesh and Extraction of the Pigment. Foods 2021, 10, 1280. https://doi.org/10.3390/foods10061280
Toma MA, Nazir KHMNH, Mahmud MM, Mishra P, Ali MK, Kabir A, Shahid MAH, Siddique MP, Alim MA. Isolation and Identification of Natural Colorant Producing Soil-Borne Aspergillus niger from Bangladesh and Extraction of the Pigment. Foods. 2021; 10(6):1280. https://doi.org/10.3390/foods10061280
Chicago/Turabian StyleToma, Maria Afroz, K H M Nazmul Hussain Nazir, Md. Muket Mahmud, Pravin Mishra, Md. Kowser Ali, Ajran Kabir, Md. Ahosanul Haque Shahid, Mahbubul Pratik Siddique, and Md. Abdul Alim. 2021. "Isolation and Identification of Natural Colorant Producing Soil-Borne Aspergillus niger from Bangladesh and Extraction of the Pigment" Foods 10, no. 6: 1280. https://doi.org/10.3390/foods10061280
APA StyleToma, M. A., Nazir, K. H. M. N. H., Mahmud, M. M., Mishra, P., Ali, M. K., Kabir, A., Shahid, M. A. H., Siddique, M. P., & Alim, M. A. (2021). Isolation and Identification of Natural Colorant Producing Soil-Borne Aspergillus niger from Bangladesh and Extraction of the Pigment. Foods, 10(6), 1280. https://doi.org/10.3390/foods10061280

